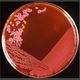
1
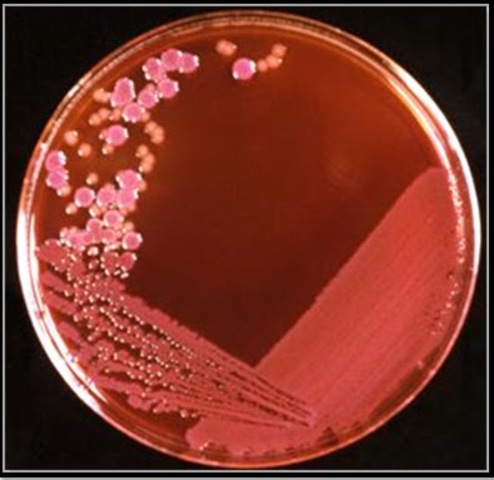

-
anton van den loski fue el creador de los lentes microbacterianos para observar las pequellas bcaterias .
-
La existencia de microorganismos ya fue hipotetizada a finales de la Edad Media. En el Canon de medicina (1020), Abū Alī ibn Sīnā (Avicenna) planteaba que las secreciones corporales estaban contaminadas por multitud de cuerpos extraños infecciosos antes de que una persona cayera enferma, pero no llegó a identificar a estos cuerpos como la primera causa de las enfermedades.
-
Robert Koch fue pionero en la microbiología médica, trabajando con diferentes enfermedades infecciosas, como el cólera, el ántrax y la tuberculosis. Koch logró probar la teoría germinal de las enfermedades infecciosas tras sus investigaciones en tuberculosis, siendo por ello galardonado con el premio Nobel en Medicina y Fisiología.
-
Louis Pasteur demostró en 1859 que los procesos de fermentación eran causados por el crecimiento de microorganismos, y que dicho crecimiento no era debido a la generación espontánea, como se suponía hasta entonces.
-
Anthony van Leeuwenhoek fue el primero en descubrir a las bacterias con un microscopio construido por él mismo. En otros tiempos se pensaba que las bacterias aparecían por generación espontánea a partir de materia inerte.
-
Louis Pasteur describió el origen bacteriano de algunas enfermedades infecciosas y de los procesos de fermentación. Fue en ese punto cuando podría decirse que inició el desarrollo de la bacteriología.
-
En 1865 Pasteur emprendió otra tarea más difícil. Las nuevas industrias francesas dependían en gran parte del abastecimiento de seda, y su producción estaba amenazada de extinguirse por una misteriosa enfermedad del gusano de seda. Pasteur fue encargado de investigar sobre ella
-
Cuando se comprendió claramente la teoría de los gérmenes y la técnica de su aplicación docenas de médicos se dedicaron a estudiar las enfermedades infecciosas, buscando el germen que as causaba y a menudo o, aunque no siempre, hallando un suero inmunizador o curativo, o indicando las precauciones necesarias para detener las epidemias. Contrarrestadas por las mejoras sanitarias empezaron a desaparecer de Europa las enfermedades de origen hídrico como el tifus y a disminuir la mortalidad infantil
-
conocimiento científico de la inmunidad frente a las bacterias: Pasteur descubrió que el Bacillus anthracis cultivado a una temperatura entre 42 y 43 °C pierde toda su virulencia tras varias generaciones, y más tarde se descubrió que los animales inoculados con estas bacterias debilitadas eran resistentes a la infección.
-
Paul Ehrlich desarrolló el primer antibiótico, por medio de unos colorantes capaces de teñir y matar selectivamente a las espiroquetas de la especie Treponema pallidum, la bacteria causante de la sífilis
Want to make a timeline like this?
Use Timetoast to turn dates, events, milestones, and phases into a clear visual timeline you can build and share. Timetoast is a timeline maker for work, school, research, and stories.